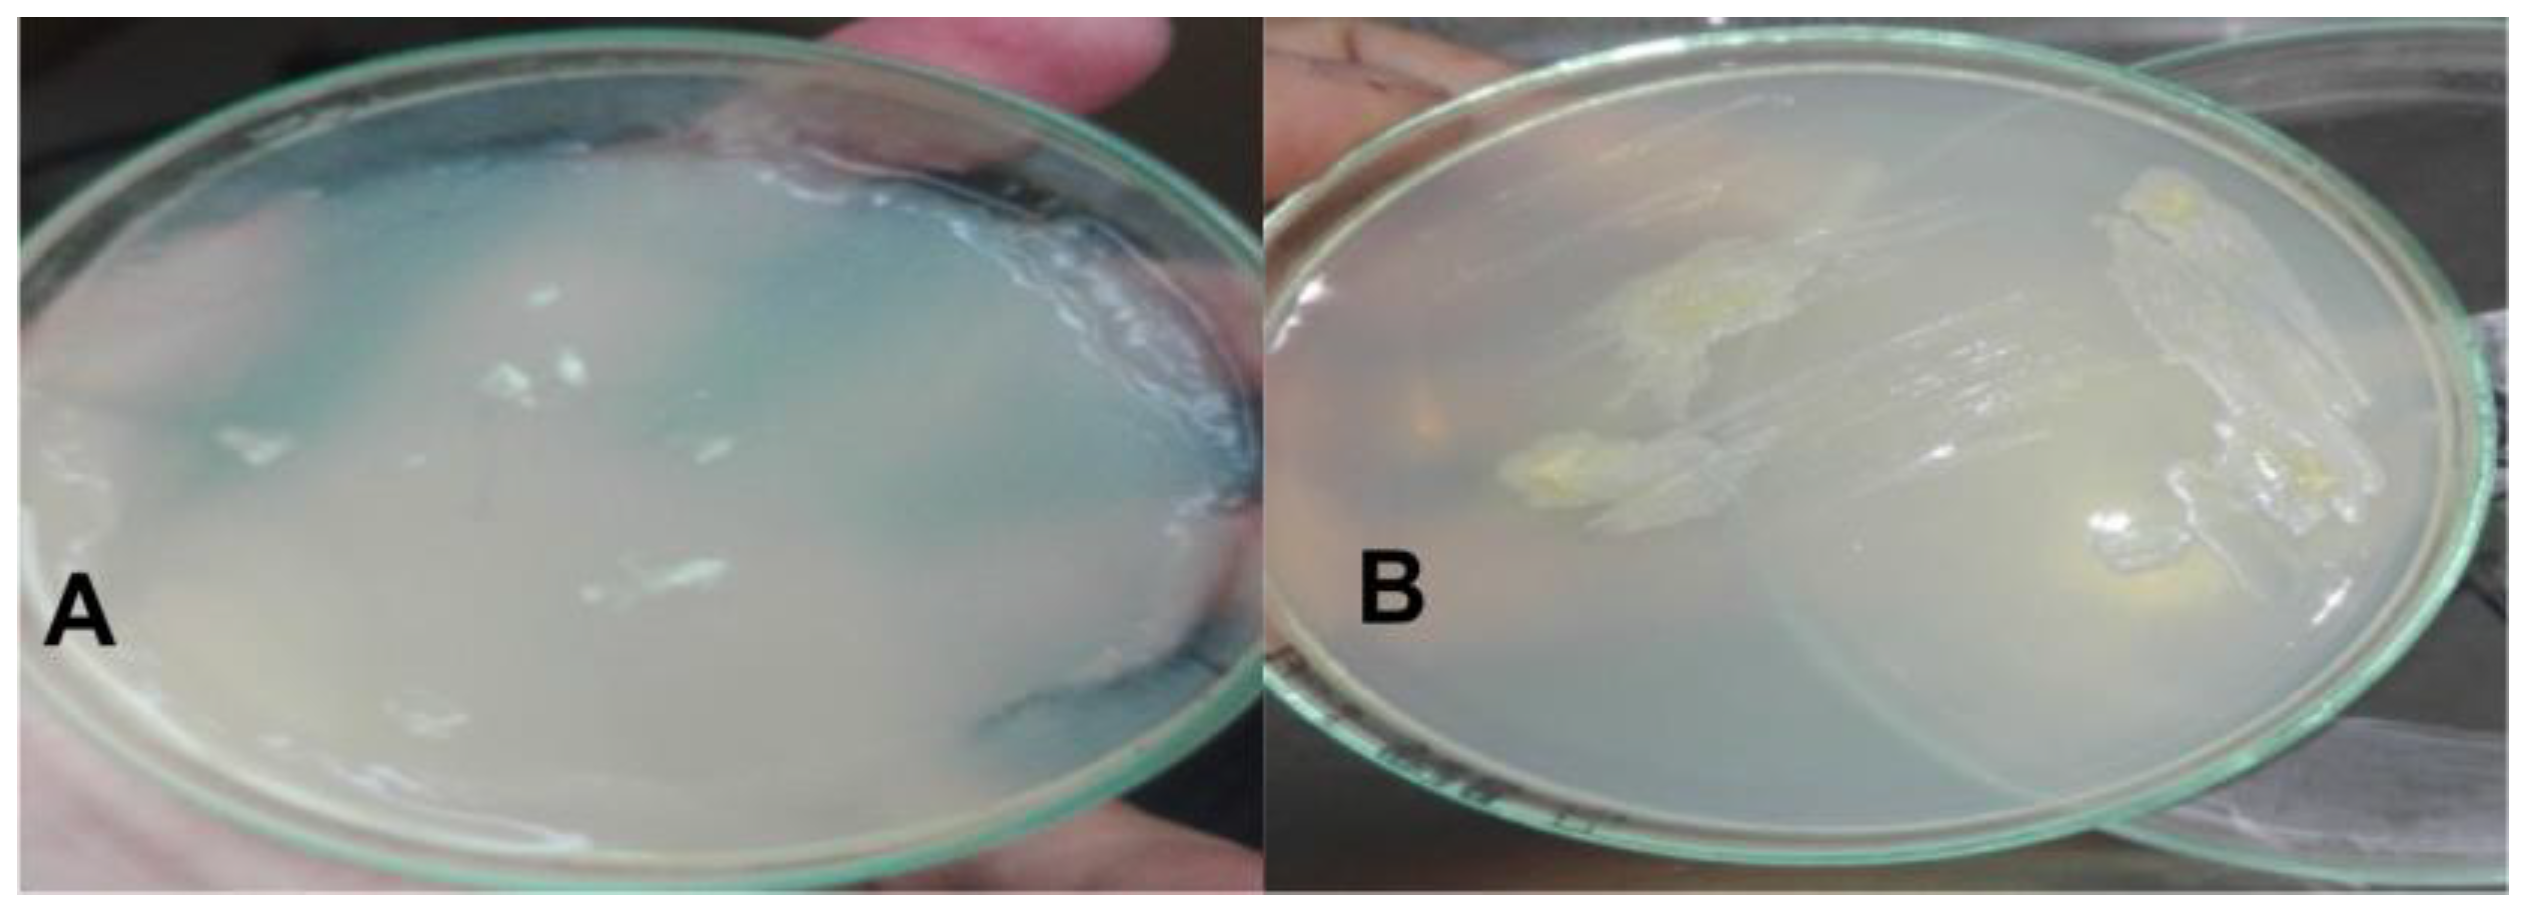
Applsci 14 00128 g001

Modulation of Growth and Antioxidative Defense Mechanism in Wheat (Triticum aestivum L.) Mediated by Plant-Beneficial Strain Pseudomonas veronii MR-15 under Drought Conditions
Abstract
:1. Introduction
2. Materials and Methods
2.1. Bacterial Isolation
2.1.1. Drought Tolerance Potential
2.1.2. Culture Preservation
2.1.3. Phosphorus Solubilization
2.1.4. Phosphate Solubilization Index (PSI)
2.1.5. Indole-3-Acetic Acid Production
2.1.6. Molecular Identification of Bacterial Isolates
2.1.7. Phylogenetic Analysis
2.2. Field Experiment
2.2.1. Bacterial Culture, Soil Analysis, Field Site, and Seed Inoculation
2.2.2. Germination Attributes
- Germination Energy (GE);
- Mean Emergence Time (MET);
- Days to 50% Emergence (E50);
- Coefficient of uniformity of emergence (CUE);
- Final germination percentage (FG%);
- Germination Index (GI).
2.2.3. Morphological Attributes
2.2.4. Photosynthetic Attributes
2.2.5. Antioxidant Enzymes
2.2.6. Non-Enzymatic Molecules with Antioxidant Function
2.2.7. Total Soluble Protein, Total Soluble Sugars, and Membrane Permeability
2.2.8. Yield Attributes
2.3. Statistical Analysis
3. Results
3.1. Physico-Chemical Identification and Characterization of Bacterial Strain MR-15
3.1.1. Screening of Drought Tolerance Potential
3.1.2. Phosphate Solubilization by MR-15
Indole Acetic Acid Production
3.1.3. Phylogenetic Analysis
3.2. Germination Response of Wheat to Inoculation with MR-15
3.3. Growth Response of Wheat to Inoculation with MR-15
3.4. Photosynthetic Pigment Response of Wheat to Inoculation with MR-15
3.5. Response of Wheat Antioxidant Enzymes to the Inoculation with MR-15
3.6. Non-Enzymatic Molecules with Antioxidant Function
3.7. Membrane Permeability Response of Wheat to Inoculation with MR-15
3.8. Yield Response of Wheat to Inoculation with MR-15
4. Discussion
5. Conclusions
Supplementary Materials
Author Contributions
Funding
Institutional Review Board Statement
Informed Consent Statement
Data Availability Statement
Acknowledgments
Conflicts of Interest
References
- Qaseem, M.F.; Qureshi, R.; Shaheen, H. Effects of pre-anthesis drought, heat and their combination on the growth, yield and physiology of diverse wheat (Triticum aestivum L.) genotypes varying in sensitivity to heat and drought stress. Sci. Rep. 2019, 9, 6955. [Google Scholar] [CrossRef] [PubMed]
- Memon, S.A.; Sheikh, I.A.; Talpur, M.A.; Mangrio, M.A. Impact of deficit irrigation strategies on winter wheat in semi-arid climate of sindh. Agric. Water Manag. 2021, 243, 106389. [Google Scholar] [CrossRef]
- Govindaraj, M.; Vetriventhan, M.; Srinivasan, M. Importance of genetic diversity assessment in crop plants and its recent advances: An overview of its analytical perspectives. Genet. Res. Int. 2015, 2015, 431487. [Google Scholar] [CrossRef] [PubMed]
- Batool, T.; Ali, S.; Seleiman, M.F.; Naveed, N.H.; Ali, A.; Ahmed, K.; Abid, M.; Rizwan, M.; Shahid, M.R.; Alotaibi, M.; et al. Plant growth promoting rhizobacteria alleviates drought stress in potato in response to suppressive oxidative stress and antioxidant enzymes activities. Sci. Rep. 2020, 10, 16975. [Google Scholar] [CrossRef] [PubMed]
- Gangadhar, B.H.; Sajeesh, K.; Venkatesh, J.; Baskar, V.; Abhinandan, K.; Yu, J.W.; Prasad, R.; Mishra, R.K. Enhanced tolerance of transgenic potato plants over-expressing non-specific lipid transfer protein-1 (StnsLTP1) against multiple abiotic stresses. Front. Plant Sci. 2016, 7, 1228. [Google Scholar] [CrossRef] [PubMed]
- Aliasgharzadeh, S.; Abbasalizad Farhangi, M.; Barzegari, M. Investigating determinants of willingness to buy genetically modified foods: An approach of structural equation modeling. Br. Food J. 2023, 125, 449–468. [Google Scholar] [CrossRef]
- Bawa, A.S.; Anilakumar, K.R. Genetically modified foods: Safety, risks and public concerns—A review. J. Food Sci. Technol. 2013, 50, 1035–1046. [Google Scholar] [CrossRef]
- Trivedi, P.; Mattupalli, C.; Eversole, K.; Leach, J.E. Enabling sustainable agriculture through understanding and enhancement of microbiomes. New Phytol. 2021, 230, 2129–2147. [Google Scholar] [CrossRef]
- Balthazar, C.; Joly, D.L.; Filion, M. Exploiting beneficial Pseudomonas spp. for cannabis production. Front. Microbiol. 2022, 12, 833172. [Google Scholar] [CrossRef]
- Notununu, I.; Moleleki, L.; Roopnarain, A.; Adeleke, R. Effects of plant growth-promoting rhizobacteria on the molecular responses of maize under drought and heat stresses: A review. Pedosphere 2022, 32, 90–106. [Google Scholar] [CrossRef]
- Zboralski, A.; Filion, M. Genetic factors involved in rhizosphere colonization by phytobeneficial Pseudomonas spp. Comput. Struct. Biotechnol. J. 2020, 18, 3539–3554. [Google Scholar] [CrossRef] [PubMed]
- Sati, D.; Pande, V.; Pandey, S.C.; Samant, M. Recent advances in PGPR and molecular mechanisms involved in drought stress resistance. J. Soil Sci. Plant Nutr. 2022, 23, 106–124. [Google Scholar] [CrossRef]
- Götze, S.; Stallforth, P. Structure elucidation of bacterial nonribosomal lipopeptides. Org. Biomol. Chem. 2020, 8, 1710–1727. [Google Scholar] [CrossRef] [PubMed]
- Etesami, H.; Maheshwari, D.K. Use of plant growth promoting rhizobacteria (PGPRs) with multiple plant growth promoting traits in stress agriculture: Action mechanisms and future prospects. Ecotoxicol. Environ. Saf. 2018, 156, 225–246. [Google Scholar] [CrossRef] [PubMed]
- Mekureyaw, M.F.; Pandey, C.; Hennessy, R.C.; Nicolaisen, M.H.; Liu, F.; Nybroe, O.; Roitsch, T. The cytokinin-producing plant beneficial bacterium Pseudomonas fluorescens G20-18 primes tomato (Solanum lycopersicum) for enhanced drought stress responses. J. Plant Physiol. 2022, 270, 153629. [Google Scholar] [CrossRef] [PubMed]
- Waghunde, R.R.; Shinde, C.U.; Pandey, P.; Singh, C. Fungal biopesticides for agro-environmental sustainability. In Industrially Important Fungi for Sustainable Development; Volume 1: Biodiversity and Ecological Perspectives; Springer International Publishing: Cham, Switzerland, 2021; pp. 479–508. [Google Scholar]
- Iftikhar, Y.; Sajid, A.; Shakeel, Q.; Ahmad, Z.; Haq, Z. Biological Antagonism: Safe and sustainable way to manage plant diseases. In Plant Disease Management Strategies for Sustainable Agriculture through Traditional and Modern Approaches; Springer: Berlin/Heidelberg, Germany, 2020; pp. 83–109. [Google Scholar]
- Nisrina, L.Y.; Effendi; Pancoro, A. Revealing the role of Plant Growth Promoting Rhizobacteria in suppressive soils against Fusarium oxysporum f. sp. cubense based on metagenomic analysis. Heliyon 2021, 7, e7636. [Google Scholar]
- El-Saadony, M.T.; Saad, A.M.; Soliman, S.M.; Salem, H.M.; Ahmed, A.I.; Mahmood, M.; El-Tahan, A.M.; Ebrahim, A.A.M.; Abd El-Mageed, T.A.; Negm, S.H.; et al. Plant growth promoting microorganisms as biocontrol agents of plant diseases: Mechanisms, challenges and future perspectives. Front. Plant Sci. 2022, 13, 923880. [Google Scholar] [CrossRef]
- Gopalan, N.R.; Sharma, R.; Mohapatra, S. Probing into the unique relationship between a soil bacterium, Pseudomonas putida AKMP7 and Arabidopsis thaliana: A case of “conditional pathogenesis”. Plant Physiol. Biochem. 2022, 183, 46–55. [Google Scholar] [CrossRef]
- Baliyan, N.; Dhiman, S.; Dheeman, S.; Kumar, S.; Maheshwari, D.K. Optimization of indole-3-acetic acid using response surface methodology and its effect on vegetative growth of chickpea. Rhizosphere 2021, 17, 100321. [Google Scholar] [CrossRef]
- Eswaran, S.U.D.; Sundaram, L.; Siang, T.C.; Alharbi, S.A.; Alahmadi, T.A.; Kadam, S.K. Multifarious microbial biostimulants promote growth in Arachis hypogaea L. Front. Sustain. Food Syst. 2023, 7, 1170374. [Google Scholar] [CrossRef]
- Yasmeen, T.; Ahmad, A.; Arif, M.S.; Mubin, M.; Rehman, K.; Shahzad, S.M.; Wijaya, L. Biofilm forming rhizobacteria enhance growth and salt tolerance in sunflower plants by stimulating antioxidant enzymes activity. Plant Physiol. Biochem. 2020, 156, 242–256. [Google Scholar] [CrossRef]
- Costa-Gutierrez, S.B.; Lami, M.J.; Santo MC, C.D.; Zenoff, A.M.; Vincent, P.A.; Molina-Henares, M.A.; de Cristóbal, R.E. Plant growth promotion by Pseudomonas putida KT2440 under saline stress: Role of eptA. Appl. Microbiol. Biotechnol. 2020, 104, 4577–4592. [Google Scholar] [CrossRef]
- García, J.E.; Maroniche, G.; Creus, C.; Suárez-Rodríguez, R.; Ramirez-Trujillo, J.A.; Groppa, M.D. In vitro PGPR properties and osmotic tolerance of different Azospirillum native strains and their effects on growth of maize under drought stress. Microbiol. Res. 2017, 202, 21–29. [Google Scholar] [CrossRef]
- Shahid, M.; Singh, U.B.; Khan, M.S.; Singh, P.; Kumar, R.; Singh, R.N.; Kumar, A.; Singh, H.V. Bacterial ACC deaminase: Insights into enzymology, biochemistry, genetics, and potential role in amelioration of environmental stress in crop plants. Front. Microbiol. 2023, 14, 1132770. [Google Scholar] [CrossRef]
- Somasegaran, P.; Hoben, H.J. Handbook for Rhizobia. Methods in Legume–Rhizobium Technology; Springer: Berlin/Heidelberg, Germany, 1994. [Google Scholar] [CrossRef]
- Pikovskaya, R.I. Mobilization of phosphorus in soil connection with the vital activity of some microbial species. Microbiologiya 1948, 17, 362–370. [Google Scholar]
- Kloeppe, J.W.; Rodríguez-Kábana, R.; Zehnder, A.W.; Murphy, J.F.; Sikora, E.; Fernández, C. Plant root-bacterial interactions in biological control of soilborne diseases and potential extension to systemic and foliar diseases. Australas. Plant Pathol. 1999, 28, 21–26. [Google Scholar] [CrossRef]
- Maniatis, T.; Fritsch, E.F.; Sambrook, J.K. Molecular Cloning: A Laboratory Manual; Cold Spring Harbor Laboratory: Cold Spring Harbor, NY, USA, 1982. [Google Scholar]
- Weisburg, W.G.; Barns, S.M.; Pelletier, D.A.; Lane, D.J. 16S ribosomal DNA amplification for phylogenetic study. J. Bacteriol. 1991, 173, 697–703. [Google Scholar] [CrossRef]
- Arnon, D.I. Copper enzymes in isolated chloroplasts. Polyphenoloxidase in Beta vulgaris. Plant Physiol. 1949, 24, 1–15. [Google Scholar] [CrossRef]
- Kirk, J.; Allen, R. Dependence of chloroplast pigment synthesis on protein synthesis: Effect of actidione. Biochem. Biophys. Res. Commun. 1965, 21, 523–530. [Google Scholar] [CrossRef]
- Chance, B.; Maehly, A.C. [136] Assay of catalases and peroxidases. Methods Enzymol. 1955, 2, 764–775. [Google Scholar]
- Beauchamp, C.; Fridovich, I. Superoxide dismutase: Improved assays and an assay applicable to acrylamide gels. Anal. Biochem. 1971, 44, 276–287. [Google Scholar] [CrossRef]
- Mukherjee, S.P.; Choudhuri, M.A. Implications of water stress-induced changes in the levels of endogenous ascorbic acid and hydrogen peroxide in Vigna seedlings. Physiol. Plant. 1983, 58, 166–170. [Google Scholar] [CrossRef]
- Julkunen-Titto, R. Phenolic constituents in the leaves of northern willows: Methods for the analysis of certain phenolics. J. Agric. Food Chem. 1985, 33, 213–217. [Google Scholar] [CrossRef]
- Chang, C.C.; Yang, M.H.; Wen, H.M.; Chern, J.C. Estimation of total flavonoid content in propolis by two complementary colorimetric methods. J. Food Drug Anal. 2002, 10, 3. [Google Scholar]
- Hodges, D.M.; Nozzolillo, C. Anthocyanin and anthocyanoplast content of cruciferous seedlings subjected to mineral nutrient deficiencies. J. Plant Physiol. 1996, 147, 749–754. [Google Scholar] [CrossRef]
- Bradford, M.M. A rapid and sensitive method for the quantitation of microgram quantities of protein utilizing the principle of protein-dye binding. Anal. Biochem. 1976, 72, 248–254. [Google Scholar] [CrossRef]
- Yoshida, S.; Forno, D.A.; Cock, J.H. Laboratory Manual for Physiological Studies of Rice; CAB International: Los Baños, Philippines, 1971. [Google Scholar]
- Velikova, V.; Brunetti, C.; Tattini, M.; Doneva, D.; Ahrar, M.; Tsonev, T. Physiological significance of isoprenoids and phenylpropanoids in drought response of Arundinoideae species with contrasting habitats and metabolism. Plant Cell Environ. 2016, 39, 2185–2197. [Google Scholar] [CrossRef]
- Carmak, I.; Horst, J.H. Effects of aluminum on lipid peroxidation, superoxide dismutase, catalase, and peroxidase activities in root tips of soybean (Glycine max). Physiol. Plant. 1991, 83, 463–468. [Google Scholar] [CrossRef]
- Steel, R.G.D.; Torrie, J.H. Principles and Procedures of Statistics. A Biometrical Approach, 2nd ed.; McGraw-Hill Kogakusha: Tokyo, Japan, 1981. [Google Scholar]
- Gaur, A.C. Physiological Functions of Phosphate Solubilizing Micro-Organisms. In Phosphate Solubilizing Micro-Organisms as Biofertilizers; Gaur, A.C., Ed.; Omega Scientific Publishers: New Delhi, India, 1990; pp. 16–72. [Google Scholar]
- Kumar, S.; Stecher, G.; Li, M.; Knyaz, C.; Tamura, K. MEGA X: Molecular Evolutionary Genetics Analysis across computing platforms. Mol. Biol. Evol. 1918, 35, 1547–1549. [Google Scholar] [CrossRef]
- Guo, J.; Qu, L.L.; Wang, L.F.; Lu, W.P.; Lu, D.L. Effects of post-silking drought stress degree on grain yield and quality of waxy maize. J. Sci. Food Agric. 2022, 103, 1530–1540. [Google Scholar] [CrossRef]
- Nguyen, H.; Thompson, A.; Costello, C. Impacts of historical droughts on maize and soybean production in the southeastern United States. Agric. Water Manag. 2023, 281, 108237. [Google Scholar] [CrossRef]
- Jing, L.; Weng, B.; Yan, D.; Yuan, F.; Zhang, S.; Bi, W.; Yan, S. Assessment of resilience in maize suitable planting areas under drought stress. Agric. Water Manag. 2023, 277, 108096. [Google Scholar] [CrossRef]
- Metwaly, E.-S.E.; Al-Yasi, H.M.; Ali, E.F.; Farouk, H.A.; Farouk, S. Deteriorating Harmful Effects of Drought in Cucumber by Spraying Glycinebetaine. Agriculture 2022, 12, 2166. [Google Scholar] [CrossRef]
- Li, Y.; Li, H.; Li, Y.; Zhang, S. Improving water-use efficiency by decreasing stomatal conductance and transpiration rate to maintain higher ear photosynthetic rate in drought-resistant wheat. Crop J. 2017, 5, 231–239. [Google Scholar] [CrossRef]
- Ejaz, S.; Batool, S.; Anjum, M.A.; Naz, S.; Qayyum, M.F.; Naqqash, T.; Ali, S. Effects of inoculation of root-associative Azospirillum and Agrobacterium strains on growth, yield and quality of pea (Pisum sativum L.) grown under different nitrogen and phosphorus regimes. Sci. Hortic. 2020, 270, 109401. [Google Scholar] [CrossRef]
- Basu, A.; Prasad, P.; Das, S.N.; Kalam, S.; Sayyed, R.Z.; Reddy, M.S.; El Enshasy, H. Plant growth promoting rhizobacteria (PGPR) as green bioinoculants: Recent developments, constraints, and prospects. Sustainability 2022, 13, 1140. [Google Scholar] [CrossRef]
- Safdar, H.; Jamil, M.; Hussain, A.; Albalawi BF, A.; Ditta, A.; Dar, A.; Aimen, A.; Ahmad, H.T.; Nazir, Q.; Ahmad, M. The effect of different carrier materials on the growth and yield of spinach under pot and field experimental conditions. Sustainability 2022, 14, 12255. [Google Scholar] [CrossRef]
- Dasgan, H.Y.; Aldiyab, A.; Elgudayem, F.; Ikiz, B.; Gruda, N.S. Effect of biofertilizers on leaf yield, nitrate amount, mineral content and antioxidants of basil (Ocimum basilicum L.) in a floating culture. Sci. Rep. 2022, 12, 20917. [Google Scholar] [CrossRef]
- Wang, L.; Yan, Y.; Lu, W.; Lu, D. Application of exogenous phytohormones at silking stage improve grain quality under post-silking drought stress in waxy maize. Plants 2021, 10, 48. [Google Scholar] [CrossRef]
- de Aquino, G.S.; Shahab, M.; Moraes, L.A.; Moreira, A. Plant growth promoting rhizobacteria increased canola yield and root system. J. Plant Nutr. 2023, 46, 1400–1406. [Google Scholar] [CrossRef]
- Zhou, B.; Jia, R.; Chen, X.; Yang, L.; Duan, M.; Xiao, F.; Liu, C. Impact of bacteria-nitrogen coupling on cotton growth and nitrogen utilization under different salt stress. Agric. Water Manag. 2023, 280, 108221. [Google Scholar] [CrossRef]
- Urooj, N.; Bano, A.; Riaz, A. Role of PGPR on the physiology of sunflower irrigated with produced water containing high total dissolved solids (TDS) and its residual effects on soil fertility, Seedlings. Agronomy 2023, 13, 315. [Google Scholar] [CrossRef]
- Grossi, C.E.M.; Fantino, E.; Serral, F.; Zawoznik, M.S.; Fernandez Do Porto, D.A.; Ulloa, R.M. Methylobacterium sp. 2A is a plant growth-promoting rhizobacteria that has the potential to improve potato crop yield under adverse conditions. Front. Plant Sci. 2020, 11, 71. [Google Scholar] [CrossRef]
- Pérez-García, L.-A.; Sáenz-Mata, J.; Fortis-Hernández, M.; Navarro-Muñoz, C.E.; Palacio-Rodríguez, R.; Preciado-Rangel, P. Plant-Growth-Promoting Rhizobacteria Improve Germination and Bioactive Compounds in Cucumber Seedlings. Agronomy 2023, 13, 315. [Google Scholar] [CrossRef]
- Stoll, A.; Salvatierra-Martínez, R.; González, M.; Cisternas, J.; Rodriguez, Á.; Vega-Gálvez, A.; Bravo, J. Importance of crop phenological stages for the effient use of PGPR inoculants. Sci. Rep. 2021, 11, 19548–19549. [Google Scholar] [CrossRef]
- Singh, R.K.; Singh, P.; Li, H.B.; Guo, D.J.; Song, Q.Q.; Yang, L.T.; Li, Y.R. Plant-PGPR interaction study of plant growth-promoting diazotrophs Kosakoniaradicincitans BA1 and Stenotrophomonas maltophilia COA2 to enhance growth and stress-related gene expression in Saccharum spp. J. Plant Interact. 2020, 15, 427–445. [Google Scholar] [CrossRef]
- Song, Q.; Song, X.; Deng, X.; Luo, J.; Wang, J.; Min, K.; Song, R. Effects of plant growth promoting Rhizobacteria microbial on the growth, rhizosphere soil properties, and bacterial community of Pinus sylvestris var. mongolica seedlings. Scand. J. For. Res. 2021, 36, 249–262. [Google Scholar] [CrossRef]
- Ye, Y.X.; Lu, D.L.; Wang, F.B.; Chen, X.H.; Qi, M.Y.; He, R.; Lu, W.P. Effects of exogenous trehalose on physiological characteristics in waxy maize seedlings under drought stress. J. Maize Sci. 2020, 28, 80–86. [Google Scholar]
- Lulsdorf, M.M.; Yuan, H.Y.; Slater, S.M.; Vandenberg, A.; Han, X.; Zaharia, L.I.; Abrams, S.R. Endogenous hormone profiles during early seed development of C. arietinum and C. anatolicum. Plant Growth Regul. 2013, 71, 191–198. [Google Scholar] [CrossRef]
- Banik, P.; Zeng, W.; Tai, H.; Bizimungu, B.; Tanino, K. Effects of drought acclimation on drought stress resistance in potato (Solanum tuberosum L.) genotypes. Environ. Exp. Bot. 2016, 126, 76–89. [Google Scholar] [CrossRef]

| Parameters | Value |
|---|---|
| Textural class | Sandy clay loam |
| pH | 8.1 |
| Bulk density (g cm−3) | 1.49 |
| Electrical conductivity (dS m−1) | 0.62 |
| Organic matter (%) | 0.58 |
| Available P (mg kg−1) | 6.7 |
| Extractable K (mg kg−1) | 128 |
| Total nitrogen (%) | 0.03 |
| Isolate Code | Colony Morphology on LB | Cell Morphology | |||
| MR-15 | Small, smooth, creamy | Short rod | |||
| Isolate code | Base pair sequence from 16S rRNA gene | Closest GenBank match | % identity | Strain identified as | GenBank accession No. |
| MR-15 | 1594 | Pseudomonas xanthomarina strain SBT1 | 98.88 | Pseudomonas veronii | OL851707 |
| Sr. No. | Strain Label | Source | PSI | IAA ppm |
|---|---|---|---|---|
| 1 | MR-15 | Rhizosphere | 2.5 | 13.31955 |
Disclaimer/Publisher’s Note: The statements, opinions and data contained in all publications are solely those of the individual author(s) and contributor(s) and not of MDPI and/or the editor(s). MDPI and/or the editor(s) disclaim responsibility for any injury to people or property resulting from any ideas, methods, instructions or products referred to in the content. |
© 2023 by the authors. Licensee MDPI, Basel, Switzerland. This article is an open access article distributed under the terms and conditions of the Creative Commons Attribution (CC BY) license (https://creativecommons.org/licenses/by/4.0/).
Share and Cite
Rehman, M.; Shahid, M.; Mahmood, S.; Ali, Q.; Azeem, M. Modulation of Growth and Antioxidative Defense Mechanism in Wheat (Triticum aestivum L.) Mediated by Plant-Beneficial Strain Pseudomonas veronii MR-15 under Drought Conditions. Appl. Sci. 2024, 14, 128. https://doi.org/10.3390/app14010128
Rehman M, Shahid M, Mahmood S, Ali Q, Azeem M. Modulation of Growth and Antioxidative Defense Mechanism in Wheat (Triticum aestivum L.) Mediated by Plant-Beneficial Strain Pseudomonas veronii MR-15 under Drought Conditions. Applied Sciences. 2024; 14(1):128. https://doi.org/10.3390/app14010128
Chicago/Turabian StyleRehman, Maryam, Muhammad Shahid, Saqib Mahmood, Qasim Ali, and Muhammad Azeem. 2024. "Modulation of Growth and Antioxidative Defense Mechanism in Wheat (Triticum aestivum L.) Mediated by Plant-Beneficial Strain Pseudomonas veronii MR-15 under Drought Conditions" Applied Sciences 14, no. 1: 128. https://doi.org/10.3390/app14010128
APA StyleRehman, M., Shahid, M., Mahmood, S., Ali, Q., & Azeem, M. (2024). Modulation of Growth and Antioxidative Defense Mechanism in Wheat (Triticum aestivum L.) Mediated by Plant-Beneficial Strain Pseudomonas veronii MR-15 under Drought Conditions. Applied Sciences, 14(1), 128. https://doi.org/10.3390/app14010128

